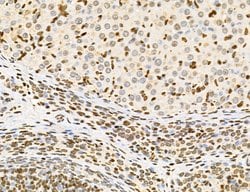

Promotional price valid on web orders only. Your contract pricing may differ. Interested in signing up for a dedicated account number?
Learn More
Learn More
Invitrogen™ Lass2 Polyclonal Antibody


Rabbit Polyclonal Antibody
Supplier: Invitrogen™ PA5115496
Description
Antibody detects endogenous levels of total LASS2.
LASS2 is a protein that has sequence similarity to yeast longevity assurance gene 1. Mutation or overexpression of the related gene in yeast has been shown to alter yeast lifespan. The human protein may play a role in the regulation of cell growth. This gene encodes a protein that has sequence similarity to yeast longevity assurance gene 1. Mutation or overexpression of the related gene in yeast has been shown to alter yeast lifespan. The human protein may play a role in the regulation of cell growth. Alternatively spliced transcript variants encoding the same protein have been described.
Specifications
| Lass2 | |
| Polyclonal | |
| Unconjugated | |
| CERS2 | |
| 0610013I17Rik; AI225939; ceramide synthase 2; CERS2; FLJ10243; L3; LAG1 homolog, ceramide synthase 2; LAG1 longevity assurance 2; LAG1 longevity assurance homolog 2; LAG1 longevity assurance homolog 2; ceramide synthase 2; LASS2; longevity assurance (LAG1, S. cerevisiae) homolog 2; longevity assurance homolog 2; MGC987; SP260; Sphingosine N-acyltransferase CERS2; TMSG1; TRAM homolog 3; translocating chain-associating membrane protein homolog 3; Trh3; Tumor metastasis-suppressor gene 1 protein | |
| Rabbit | |
| Antigen affinity chromatography | |
| RUO | |
| 29956, 310667, 76893 | |
| -20°C | |
| Liquid |
| Immunohistochemistry (Paraffin), Western Blot, Immunocytochemistry | |
| 1 mg/mL | |
| PBS with 50% glycerol and 0.02% sodium azide | |
| Q924Z4, Q96G23 | |
| CERS2 | |
| A synthesized peptide derived from human CERS2(Accession Q96G23), corresponding to amino acid residues T346-D380. | |
| 100 μL | |
| Primary | |
| Human, Mouse, Rat | |
| Antibody | |
| IgG |
Safety and Handling
WARNING: Cancer - www.P65Warnings.ca.gov
Product Content Correction
Your input is important to us. Please complete this form to provide feedback related to the content on this product.
Product Title
Spot an opportunity for improvement?Share a Content Correction